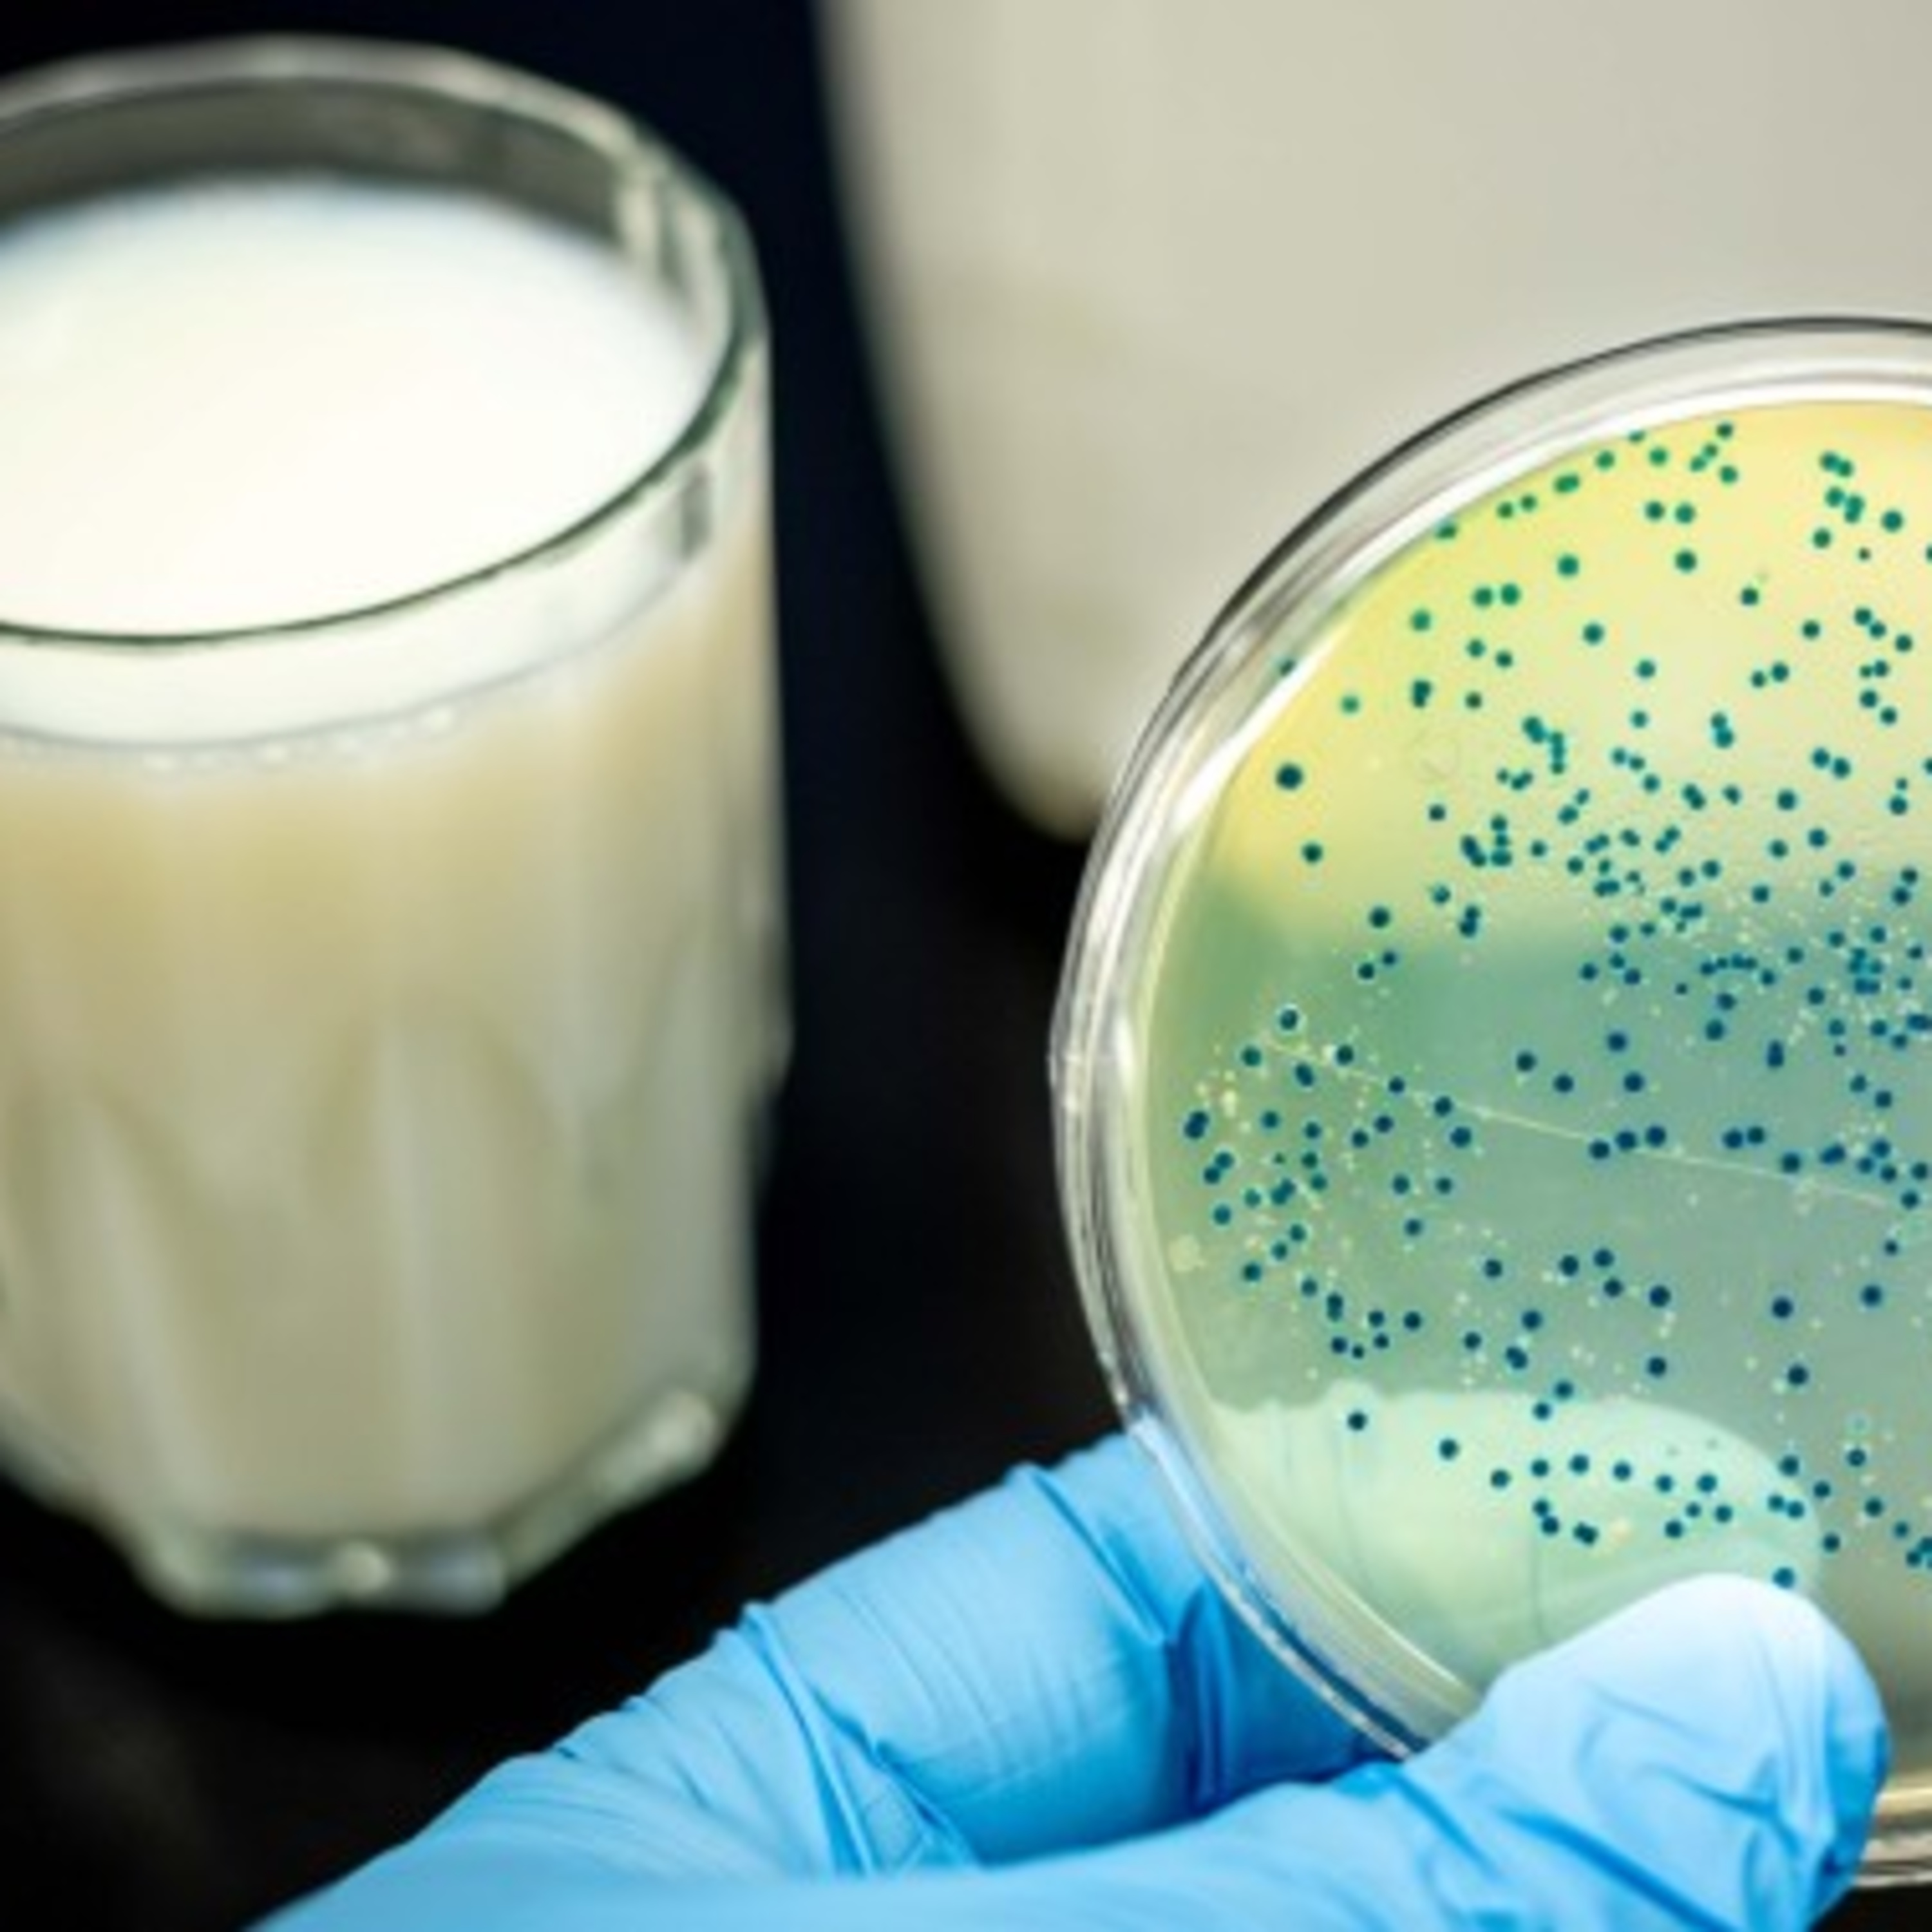
#13 استهلاك اللبن و الرايب و أخطار مرض الحمى المالطية في شهر رمضان

Welcomeمرحبا بك Bienvenue FoodCast .TN
أول بودكاست تونسي لتوعية المستهلك حول إختيار المواد الغذائية و حلول للأكل الصحي مع مهندس بيولوجي مختص في الجودة الغذائية
1er Podcast Tunisien dédié à l’amélioration des habitudes de consommations et le choix des produits alimentaires avec un ingénieur en biologie spécialiste en qualité alimentaire
الحلقات الأخيرة
Derniers épisodes de FoodCast.TN
DES PODCASTS DE PROFESSIONNELS POUR MANGER SAIN ET MIEUX CONSOMMER
Articles tendances
Explorer les articles tendances.
اكتشف مقالاتنا الخاصة
العدوى الجديدة ببكتيريا الشيغيلا: تواجدها في الأطعمة والماء و ماهي أهم الاحتياطات منها؟
حذرت وزارة الصحة من بكتيريا الشيغيلا التي انتشرت المدة الأخيرة في الأوساط المدرسية و رياض الأطفال. والشيغيلا هي بكتيريا وليست فيروس كالكوفيد, هي ليست بكتيريا جديدة و متواجدة من قبل, لكن كتتم العدوى بطريقة
بحث علمي ياكد وجود سموم فطرية بنسب عالية في حبات القهوة الموجودة بالسوق التونسية و خطرها على صحة المستهلك
الميكوتكسين او السموم الفطرية هي مركبات سامة تُنتجها بعض أنواع الفطريات بطريقة طبيعية. والعفن الذي يمكنه إنتاج السموم الفطرية ينمو على العديد من الأغذية مثل الحبوب والفاكهة المجففة والثمار الجوزية وايضا القهوة ... ويمكن
السكّر الخفي في المواد المصنعة الغدائية
.السكر عامة نوعان : النوع الأوّل هو السكر الأبيض الذي يستخرج من قصب السكر أو الشمندر، أمّا النوع الثاني هو السكر الخفي الموجود في الأغدية و الصناعات الغذائية عامة وللسكر أسماء كثيرة مثل "
ما هي فوائد ومضار شرب القهوة عامة و هل يمكن تناول القهوة بعد الإفطار مباشرة او قبل النوم في السحور ؟
ما هي فوائد ومضار شرب القهوة عامة و هل يمكن تناول القهوة بعد الإفطار مباشرة او قبل النوم في السحور ؟ تعتبر القهوة اكثر السوائل استهلاكا في العالم بعد الماء و قبل الشاي و من
استهلاك اللبن و الرايب و أخطار مرض الحمى المالطية في شهر رمضان
استهلاك اللبن و الرايب و أخطار مرض الحمى المالطية في شهر رمضان تدعوا وزارة الصحة في كل سنة، إلى عدم استهلاك منتوجات الألبان غير المعقمة خلال شهر رمضان، من أجل تفادي ارتفاع الإصابات المسجلة
Kinder contaminés aux salmonelles : La Tunisie est elle épargnée?
Kinder contaminés aux salmonelles : La Tunisie est elle épargnée? Ferrero rappelle plusieurs produits de ses chocolat Kinder en raison d'une potentielle contamination à la salmonelle. Ces rappels font suite à une potentielle épidémie de
العدوى الجديدة ببكتيريا الشيغيلا: تواجدها في الأطعمة والماء و ماهي أهم الاحتياطات منها؟
حذرت وزارة الصحة من بكتيريا الشيغيلا التي انتشرت المدة الأخيرة في الأوساط المدرسية و رياض الأطفال. والشيغيلا هي بكتيريا وليست فيروس كالكوفيد, هي ليست بكتيريا جديدة و متواجدة من قبل, لكن كتتم العدوى بطريقة
بحث علمي ياكد وجود سموم فطرية بنسب عالية في حبات القهوة الموجودة بالسوق التونسية و خطرها على صحة المستهلك
الميكوتكسين او السموم الفطرية هي مركبات سامة تُنتجها بعض أنواع الفطريات بطريقة طبيعية. والعفن الذي يمكنه إنتاج السموم الفطرية ينمو على العديد من الأغذية مثل الحبوب والفاكهة المجففة والثمار الجوزية وايضا القهوة ... ويمكن
السكّر الخفي في المواد المصنعة الغدائية
.السكر عامة نوعان : النوع الأوّل هو السكر الأبيض الذي يستخرج من قصب السكر أو الشمندر، أمّا النوع الثاني هو السكر الخفي الموجود في الأغدية و الصناعات الغذائية عامة وللسكر أسماء كثيرة مثل "
ما هي فوائد ومضار شرب القهوة عامة و هل يمكن تناول القهوة بعد الإفطار مباشرة او قبل النوم في السحور ؟
ما هي فوائد ومضار شرب القهوة عامة و هل يمكن تناول القهوة بعد الإفطار مباشرة او قبل النوم في السحور ؟ تعتبر القهوة اكثر السوائل استهلاكا في العالم بعد الماء و قبل الشاي و من
Également disponible sur
Notre contenu de podcast est également disponible sur les plateformes suivantes:
البودكاست متاح أيضا على المنصات التالية